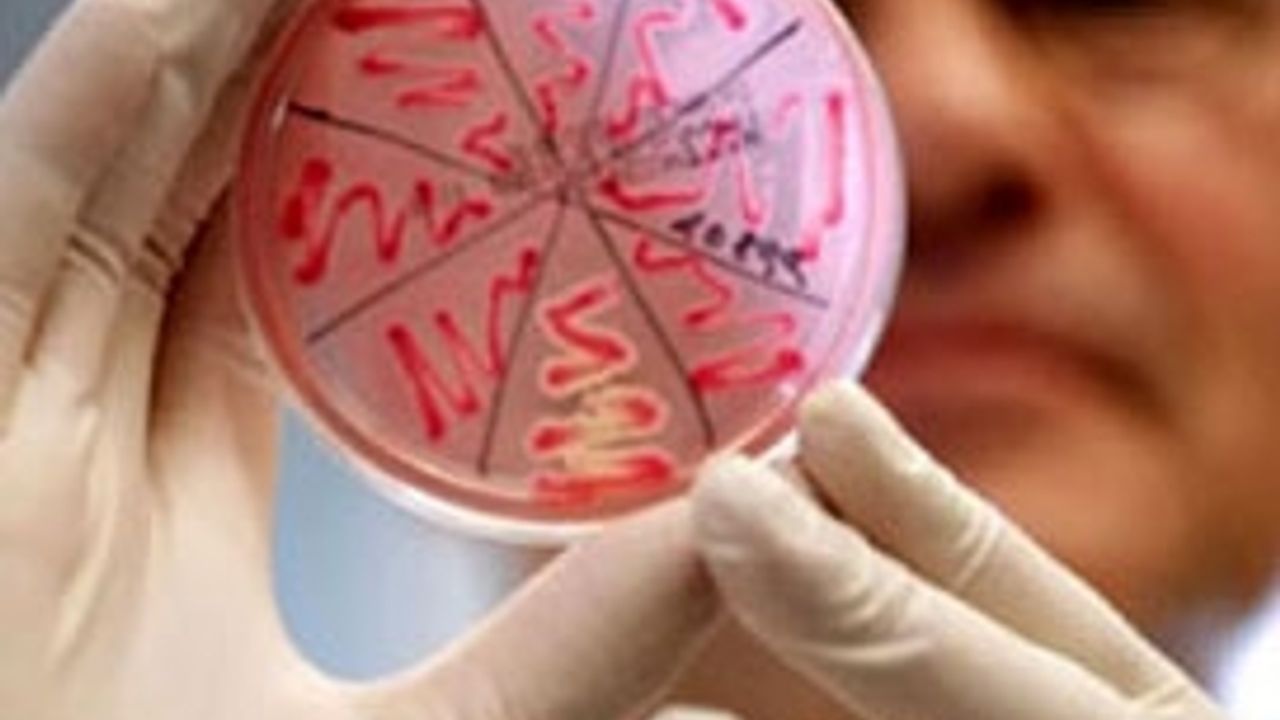

Endonezya Sağlık Bakanlığı'ndan yapılan açıklamada, 19 yaşındaki bir kadının başkent Cakarta'nın batısında 13 Şubat'ta öldüğü belirtildi.
Bu ölümle, Endonezya'da sene başından bu yana kuş gribinden yaşamını yitirenlerin sayısı 3'e çıktı.
Haber Kaynağı : Haber7.com